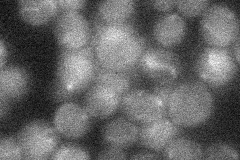
YCR075C

View description
Protein with similarity to human cystinosin, which is a H(+)-driven transporter involved in L-cystine export from lysosomes and implicated in the disease cystinosis; contains seven transmembrane domains
Localization:
Intensity:
Fold change:
Significance:
-
C’ GFP library in SD

below threshold15.33 -
N' NOP1pr-GFP in SD

below threshold21.5164 -
N' TEF2pr-mCherry in SD

vacuole10.1116 -
N' NATIVEpr-GFP in SD
below threshold18.0149 -
N' TEF2pr-VC and Cyto-VN in SD

below threshold24.226 -
C’ GFP library in SD+DTT

cytosol16.451.07No -
C’ GFP library in SD+H2O2

cytosol13.740.89No -
C’ GFP library in Starvation Media

cytosol22.361.45No -
C’ GFP library on the background of Pup2-DaMP

below threshold -
C’ GFP library on the background of CCT mutant

below threshold14.55450.948743No
